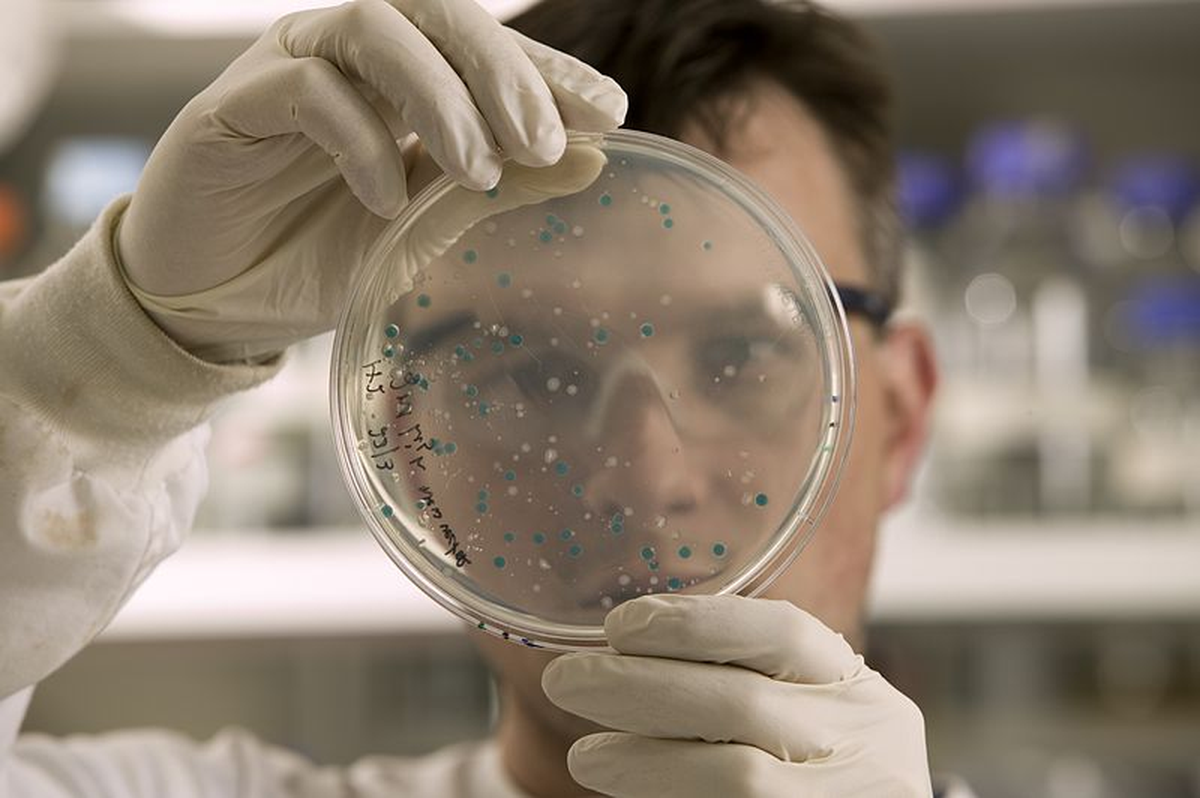
Las proteínas podrían ser un punto esencial. Las proteínas podrían ser un punto esencial.

Seis de los científicos más importantes de Canadá se reunieron en el Perimeter Institute for Theoretical Physics para imaginar cómo la ciencia va a revolucionar el mundo. Las predicciones van desde humanos con implantes cerebrales hasta proteínas creadas por microbios en laboratorios. El futuro que describen está más cerca de lo que imaginás.
80% PROBABLE
Científicos revelaron cómo será el mundo en 50 años: Humanos biónicos y alimentos de laboratorio
Científicos canadienses predicen cambios radicales en medicina, agricultura y energía que transformarán completamente la vida humana en este mundo.
Quizás te interese leer: Alarma total: Científicos descubrieron algo escalofriante en el fondo del océano antártico
Superhombres con exoesqueletos y cerebros conectados, según científicos
El evento formó parte de la celebración del 50° aniversario de Quirks & Quarks, el programa científico de CBC Radio. Los expertos coincidieron en que los avances más impactantes estarán en áreas clave: alimentación, energía, medicina genómica, robótica y astrofísica.
Ana Luisa Trejos, profesora de ingeniería en la Universidad de Western, aseguró que la robótica podría convertir a las personas en "superhumanos". Los exoesqueletos portátiles, dispositivos mecánicos que se adaptan al cuerpo de cada individuo, permitirán no solo recuperar movilidad perdida sino amplificar capacidades físicas naturales.
Lo más sorprendente es que algunos de estos sistemas usarán implantes cerebrales para detectar la intención de movimiento. Así, las prótesis funcionarán como extremidades naturales. Trejos incluso imaginó un futuro donde prendas llenas de sensores amplifican el rendimiento humano "mucho más allá" de nuestras habilidades actuales.
Alimentos sin granjas y energía limpia en cada casa
Evan Fraser, director del Instituto de Alimentos Arrell, explicó que alimentar a 10.300 millones de personas (proyección para 2080) sin destruir el planeta será "uno de los grandes desafíos de la generación". La solución pasa por la "fermentación de precisión": microbios modificados genéticamente que producen proteínas como leche, grasa de cerdo o suero, usando menos tierra, agua y energía que la agricultura tradicional.
En paralelo, Laura Tozer, profesora de estudios ambientales en la Universidad de Toronto, anticipó un futuro donde la energía solar y eólica estarán integradas en todos los hogares canadienses, desde casas rurales hasta edificios de apartamentos. El desafío es modernizar la red eléctrica para soportar esta transformación energética total.
¿Qué tan confiables son estas predicciones?
La historia de las predicciones científicas es un arma de doble filo. En los años 70, algunos pronósticos resultaron certeros: la Ley de Moore de 1965 anticipó el crecimiento exponencial de la informática, y científicos como Arthur C. Clarke acertaron con las comunicaciones satelitales. Pero hubo fracasos monumentales: nadie predijo internet tal como lo conocemos, y muchos subestimaron la revolución de las computadoras personales.
Las predicciones de hoy tienen una ventaja crucial: los científicos trabajan con tecnologías que ya existen en forma preliminar. Los exoesqueletos, la fermentación de precisión y la medicina genómica no son fantasías, sino desarrollos en laboratorios actuales. Sin embargo, el error histórico más común fue no anticipar las barreras económicas, políticas y sociales que frenan o aceleran los avances.
La tecnología puede estar lista, pero ¿lo estará la sociedad?
-------------------------------------------------------------------------------
Más contenido en Urgente24
Tiene 6 episodios y es la miniserie más inteligente y entretenida del momento
Total (a)normalidad: Milei rockstar, y si hay crisis que no se note
Faltan 20 para el 26/10: Javier Milei, Diego Santilli y el tiempo perdido